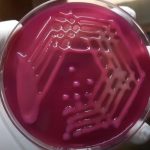
K pneumoniae: Introduction, Classification, Pathogenicity, Laboratory Diagnosis and Treatment

Category: Uncategorized
K pneumoniae: Introduction, Classification, Pathogenicity, Laboratory Diagnosis and Treatment
Introduction of K pneumoniae Klebsiella is from the surname of German-Swiss...
Introduction of K pneumoniae Klebsiella is from the surname of German-Swiss...
Fungus Preservation Techniques: Introduction, Types and Details About Sterile Water Preservation Technique
 Fungus Preservation Techniques The main objectives of fungal culture are...
Fungus Preservation Techniques The main objectives of fungal culture are...
Bacterial Capsule Demonstration Using Negative Staining Method: Introduction, Principle, Procedure, Result Interpretation and Keynotes
 Introduction of Bacterial Capsule Demonstration The capsule is the outermost layer...
Introduction of Bacterial Capsule Demonstration The capsule is the outermost layer...
